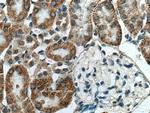
RDH10 Antibody in Immunohistochemistry (Paraffin) (IHC (P))

Search
Proteintech
RDH10 Polyclonal Antibody
{{$productOrderCtrl.translations['antibody.pdp.commerceCard.promotion.promotions']}}
{{$productOrderCtrl.translations['antibody.pdp.commerceCard.promotion.viewpromo']}}
{{$productOrderCtrl.translations['antibody.pdp.commerceCard.promotion.promocode']}}: {{promo.promoCode}} {{promo.promoTitle}} {{promo.promoDescription}}. {{$productOrderCtrl.translations['antibody.pdp.commerceCard.promotion.learnmore']}}
产品信息
14644-1-AP
种属反应
已发表种属
宿主/亚型
分类
类型
抗原
偶联物
形式
浓度
规格
纯化类型
保存液
内含物
保存条件
运输条件
产品详细信息
Immunogen sequence: VRPKEKSVA GQVCLITGAG SGLGRLFALE FARRRALLVL WDINTQSNEE TAGMVRHIYR DLEAADAAAL QAGNGEEEIL PHCNLQVFTY TCDVGKRENV YLTAERVRKE VGEVSVLVNN AGVVSGHHLL ECPDELIERT MMVNCHAHFW TTKAFLPTML EINHGHIVTV ASSLGLFSTA GVEDYCASKF GVVGFHESLS HELKAAEKDG IKTTLVCPYL VDTGMFRGCR IRKEIEPFLP PLKPDYCVKQ AMKAILTDQP MICTPRLM (27-293 aa encoded by BC067131 )
靶标信息
RDH10 generates all-trans retinal from all-trans retinol and may plan an important role in the photic visual cycle. All-trans retinal is isomerized to 11-cis retinal by the retinal G protein-coupled receptor (RGR; MIM 600342) when the retinal pigment epithelium (RPE) is illuminated.
仅用于科研。不用于诊断过程。未经明确授权不得转售。
生物信息学
蛋白别名: Retinol dehydrogenase 10; retinol dehydrogenase 10 (all-trans); Short chain dehydrogenase/reductase family 16C member 4
基因别名: 3110069K09Rik; 4921506A21Rik; AI875664; AW549993; D1Ertd762e; m366Asp; RDH10; SDR16C4; UNQ9375/PRO34191
UniProt ID: (Human) Q8IZV5, (Rat) Q80ZF7, (Mouse) Q8VCH7
Entrez Gene ID: (Human) 157506, (Rat) 353252, (Mouse) 98711